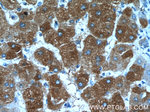
SMU1 Antibody in Immunohistochemistry (Paraffin) (IHC (P))
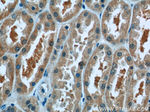
SMU1 Antibody in Immunohistochemistry (Paraffin) (IHC (P))
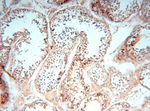
SMU1 Antibody in Immunohistochemistry (Paraffin) (IHC (P))

Search
Proteintech
SMU1 Polyclonal Antibody
{{$productOrderCtrl.translations['antibody.pdp.commerceCard.promotion.promotions']}}
{{$productOrderCtrl.translations['antibody.pdp.commerceCard.promotion.viewpromo']}}
{{$productOrderCtrl.translations['antibody.pdp.commerceCard.promotion.promocode']}}: {{promo.promoCode}} {{promo.promoTitle}} {{promo.promoDescription}}. {{$productOrderCtrl.translations['antibody.pdp.commerceCard.promotion.learnmore']}}
产品信息
15511-1-AP
种属反应
宿主/亚型
分类
类型
抗原
偶联物
形式
浓度
规格
纯化类型
保存液
内含物
保存条件
运输条件
产品详细信息
This antibody is a rabbit polyclonal antibody raised against a region of human REDD1 antigen.
Immunogen sequence: ISASSDGTV KIWNMKTTEC SNTFKSLGST AGTDITVNSV ILLPKNPEHF VVCNRSNTVV IMNMQGQIVR SFSSGKREGG DFVCCALSPR GEWIYCVGED FVLYCFSTVT GKLERTLTVH EKDVIGIAHH PHQNLIATYS EDGLLKLWKP (365-513 aa encoded by BC002876)
靶标信息
SMU1 (suppressor of Mec8 and Unc-52 homolog), also known as BWD (brain-enriched WD), is a member of the WD-repeat SMU1 family and contains one CTLH domain, one LisH domain and six WD-repeats. SMU1 is a homolog of the C. elegans protein Smu1, a ubiquitously expressed nuclear protein that is believed to play a role in alternative splicing events of Unc-52. In mammals, SMU1 is a component of the spliceosome and appears to exhibit a conserved function, affecting the splicing of the mammalian Unc-52 homolog, namely Perlecan. Mutations in the gene encoding SMU1 may affect the function of the spliceosome.
仅用于科研。不用于诊断过程。未经明确授权不得转售。
篇参考文献 (0)
生物信息学
蛋白别名: Brain-enriched WD repeat-containing protein; brain-enriched WD-repeat protein; DNA replication regulator and spliceosomal factor; functional spliceosome-associated protein 57; homolog of C. elegans smu-1; smu-1 suppressor of mec-8 and unc-52 homolog; Smu-1 suppressor of mec-8 and unc-52 protein homolog; suppressor of Mec and Unc defects 1 homolog; unnamed protein product; WD40 repeat-containing protein SMU1; WD40 repeats; ubiquitin E3 ligase
基因别名: 2600001O03Rik; 2610203K23Rik; AB044414; AI845086; AW556129; BWD; fSAP57; SMU-1; SMU1
UniProt ID: (Human) Q2TAY7, (Mouse) Q3UKJ7, (Rat) Q99M63
Entrez Gene ID: (Human) 55234, (Mouse) 74255, (Rat) 117541